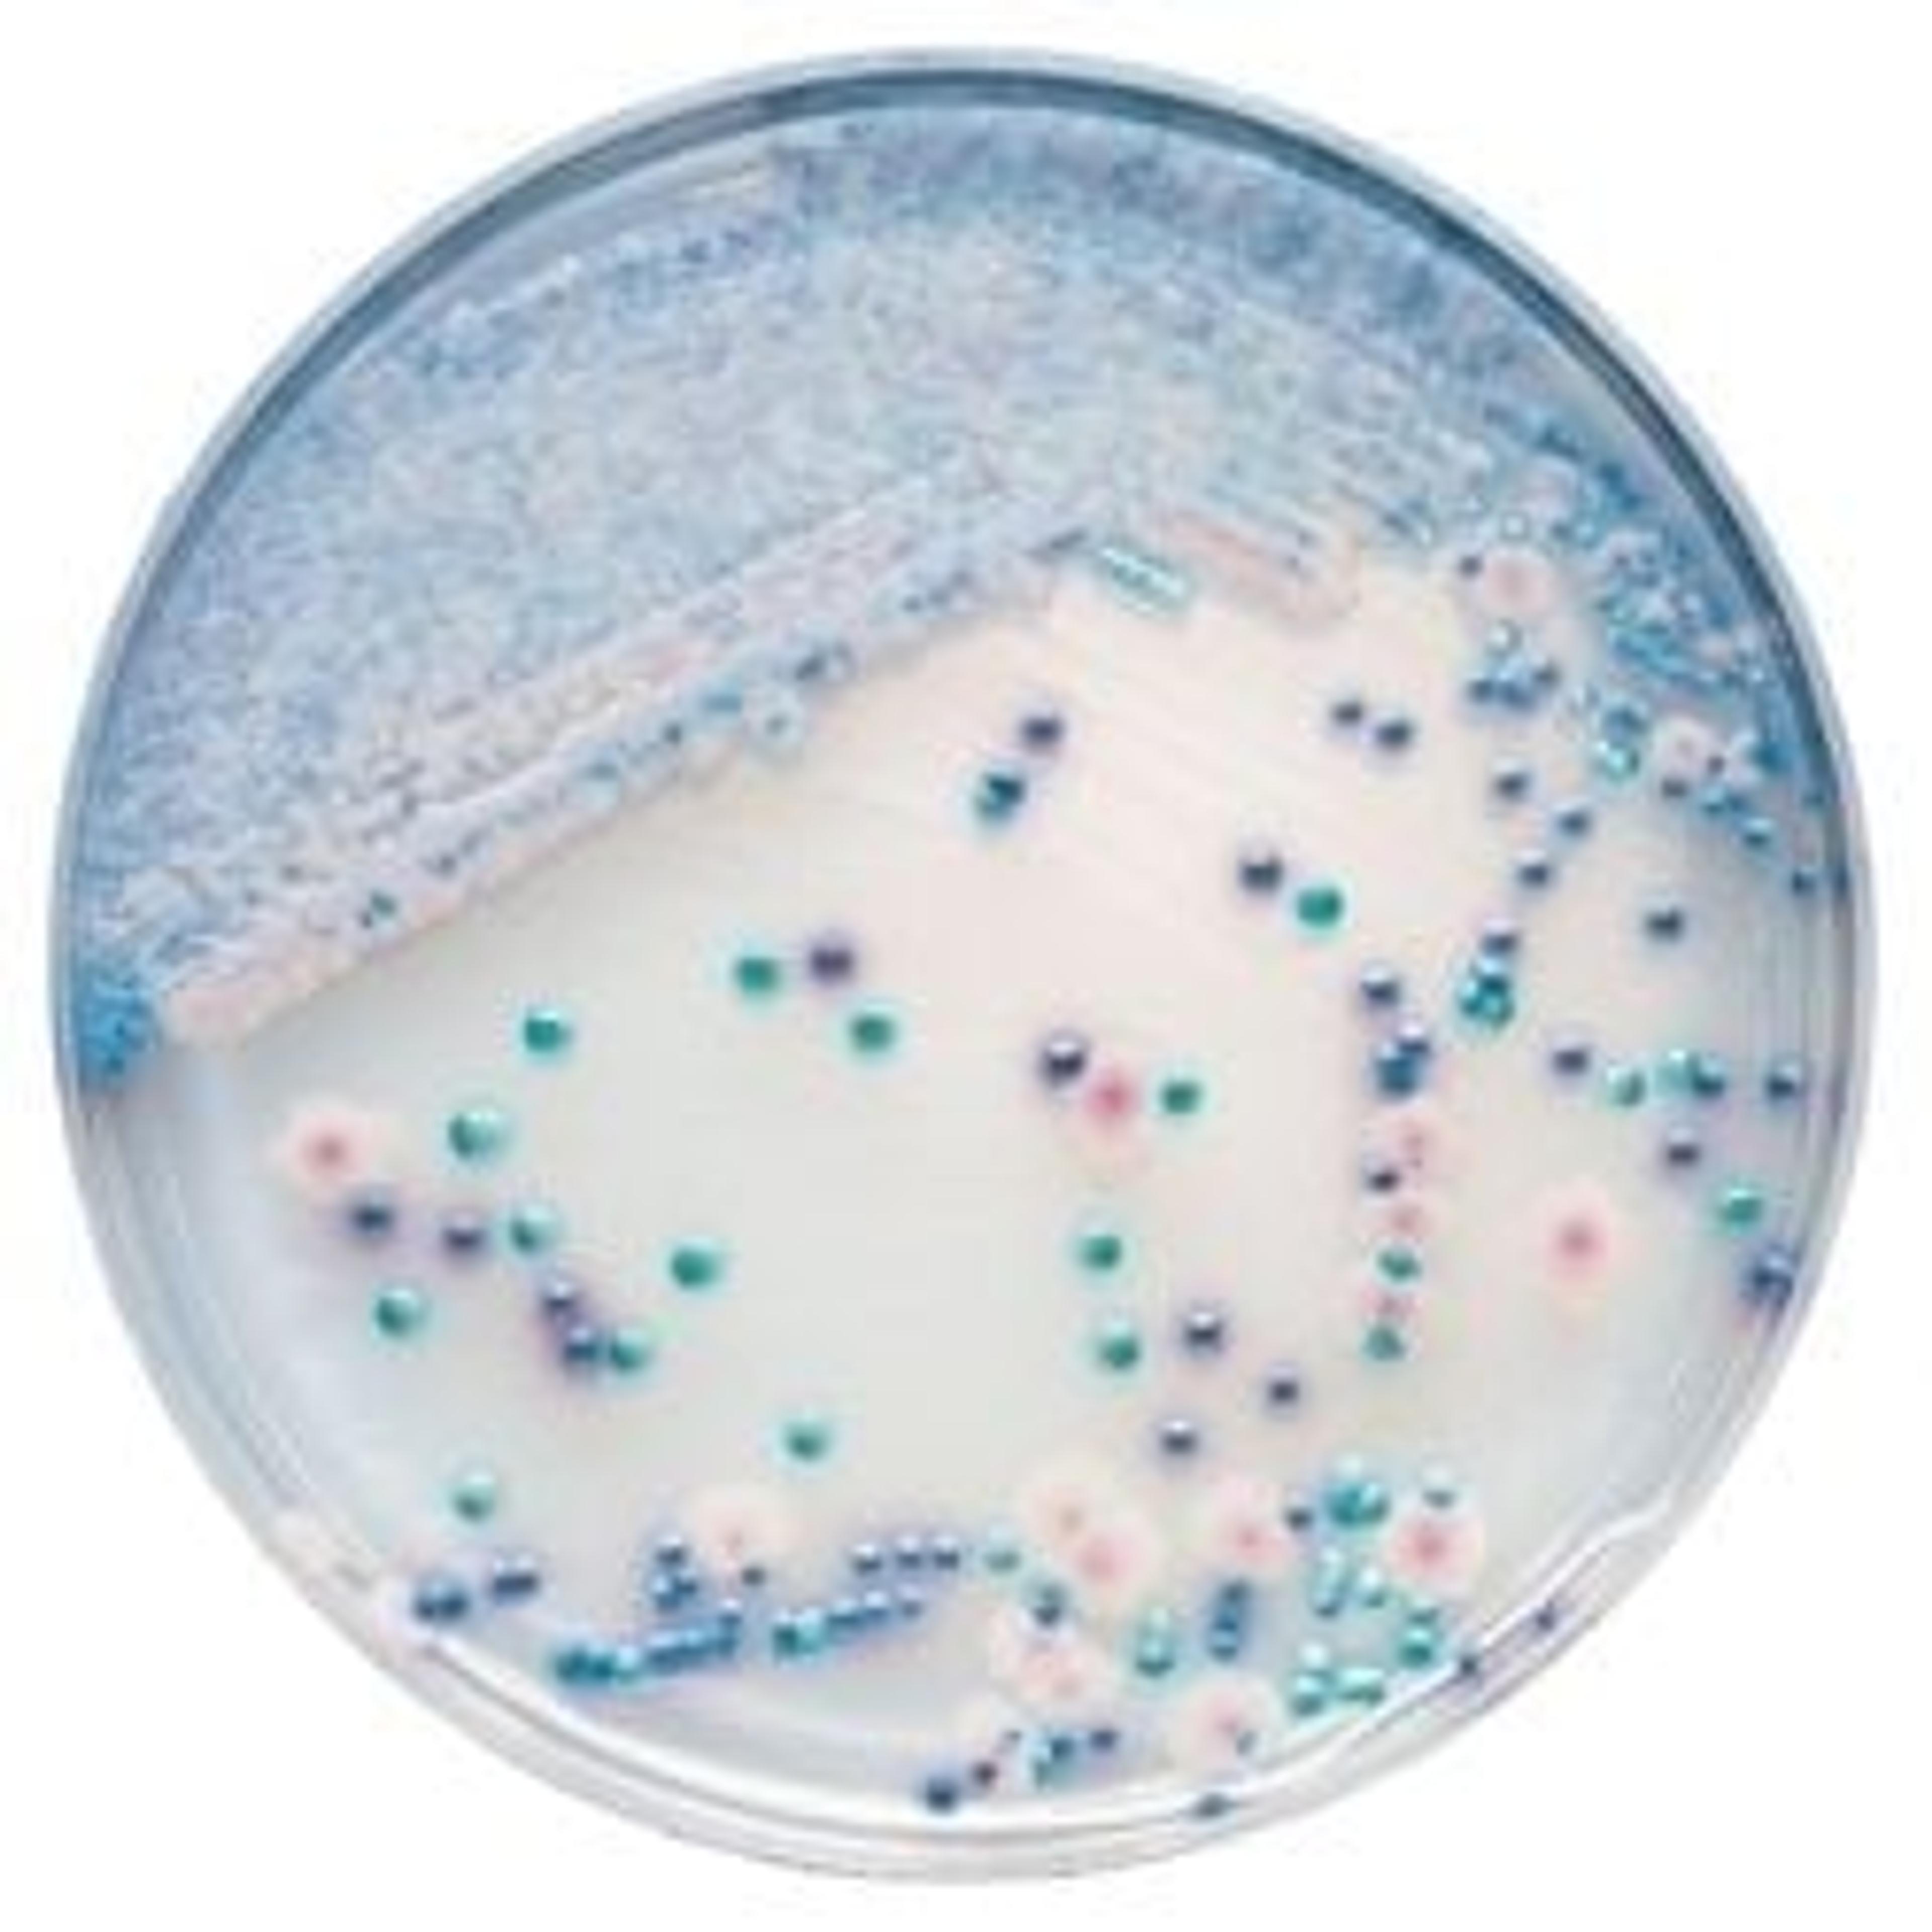
BD BBL™ CHROMagar™ Candida Plate

BD BACTEC™ FX System
BD Life SciencesThe BD BACTEC™ FX blood culture system builds on the proven history of previous BD BACTEC™ instrumentation, with advanced fluorescence detection technology, exceptional media performance and instrument reliability—adding vial-activated workflow, advanced ergonomics, blood culture observation and customer-focused data management. The easy-to-use workflow comes in a compact, modular design, which can be adapted to multiple space…